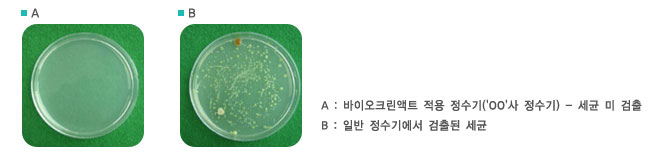

|
◎
적용
사례
|
| |
|
Cosmetic360 Open Innovation Video
|
| |
|
 |
 |
|
유아용
항균
지퍼백
|
주방용
항균
보관팩
&
유아용
항균
지퍼백
|
 |
 |
|
유아용
항균
지퍼백
|
항균
물티슈
포장재
|
|

|

|
|
음식용
항균
지퍼백
|
식품포장용
항균 필름
|
|

|

|
|
식품용
항균
포장팩
|
식품용
항균
포장용기
|
|

|

|
|
농업용
수박
항균비닐
(나라장터-국가종합조달상품)
|
항균
롤백
|
|

|

|
|
자동차필터용 PE
항균
부직포
방사용
|
자동차내장재
항균
부품들
|
|

|

|
|
자동차
손잡이
등
항균
플라스틱
사출품
|
자동차내장재
플라스틱
항균
내장재
|
|

|

|
|
전시용
항균
식기,
수통
|
함정,
잠수함
정수
담수화
항균필터,탱크
|
|

|

|
|
군납용
항균-소취
기능성
도마(성능인증제품)
|
전자랜지
트레이
가전제품
등
|
|

|

|
|
정수기
항균 Water
bottle
|
항균
플라스틱
용기
등
|
|

|

|
|
정수기
항균 콕크
등
|
무방부재용
항균 화장품
용기
등
|
|

|

|
|
생체
의료용
인체삽입용
항균
카테터
등
|
여성위생용
탐폰케이스
등
|
|

|

|
|
항균
욕실용품
|
항균
비데,
샤워커튼
등
|
|

|

|
|
컴퓨터
항균
키보드
|
컴퓨터
항균
마우스
|
|

|

|
|
핸드폰
항균
케이스
|
유아용
항균
장난감류
|
|

|

|
|
에어워셔
|
제습기
|
|

|

|
|
에어워셔
|
제습기
|
|

|

|
|
시스템
에어컨
|
공조기
모듈
|
|

|

|
|
물탱크
|
페인트통
|
|

|

|
| 컵 |
애완동물용 항균기능성디지털 식사분배기 |
 |
 |
| 정수용 필터 |
식기건조대 |
 |
 |
모유 저장팩 |
항균피팅파이핑 |
 |
 |
항균부직포 |
항균부직포
|
 |
 |
| 항균실(장섬유) |
인조잔디 |
이외에도
실제
여러
산업분야에
다양하게
적용되어
제품화에
성공하였음.(당사제품적용
실물사진임)
|
|
◎
적용
예 1.
("00"사
정수기용
물탱크)
|
|
| ▶
항균마스터배치(제품코드번호 : BCA-502MB) 3% 첨가, 사출(170℃∼190℃)한
정수기물통시편항균효과보기 |
 |
|
▶
사출한 정수기 물탱크를 실제 연구소에 설치 후 지속적인 항균효능 실험
일정 기간 후 각 정수기에서 10ml 씩 물을 채취 후 패트리 디쉬에서 4일
배양. (unit : CFU/ml) |
| 기간 |
MST
항균정수기*(정수) |
일반 정수기 (정수) |
일반 정수기 (생수) |
| 1 주일 |
0 |
1,007 |
270 |
| 2 주일 |
0 |
899 |
125 |
| 3 주일 |
0 |
1,090 |
367 |
| 1 개월 |
0 |
1,227 |
543 |
| 2 개월 |
0 |
850 |
210 |
| 3 개월 |
0 |
1,460 |
230 |
| 5 개월 |
0 |
2,330 |
640 |
| 6 개월 |
0 |
3,870 |
320 |
|
|
*
바이오크린액트 항균마스터배치로 제조한 정수조를 설치한 정수기
(MST 항균정수기)
<식품 의약품 안전청 고시 먹는물 일반세균 허용 기준 : 100 CFU
/ ㎖ 이하.> |
|
|
|
◎
적용
예 2
("S"사
항균
필름)
|
|
 |
|
|
◎
적용
예 3
("D"사
육가공
포장재)
|
|
 |
|
|
◎
적용
예 4
("C",
"D"사
항균
도마)
|
|
 |
|
기타
당사의
항균마스터배치를
적용한
제품들
수백종
상업화
완료함. |
|
|

